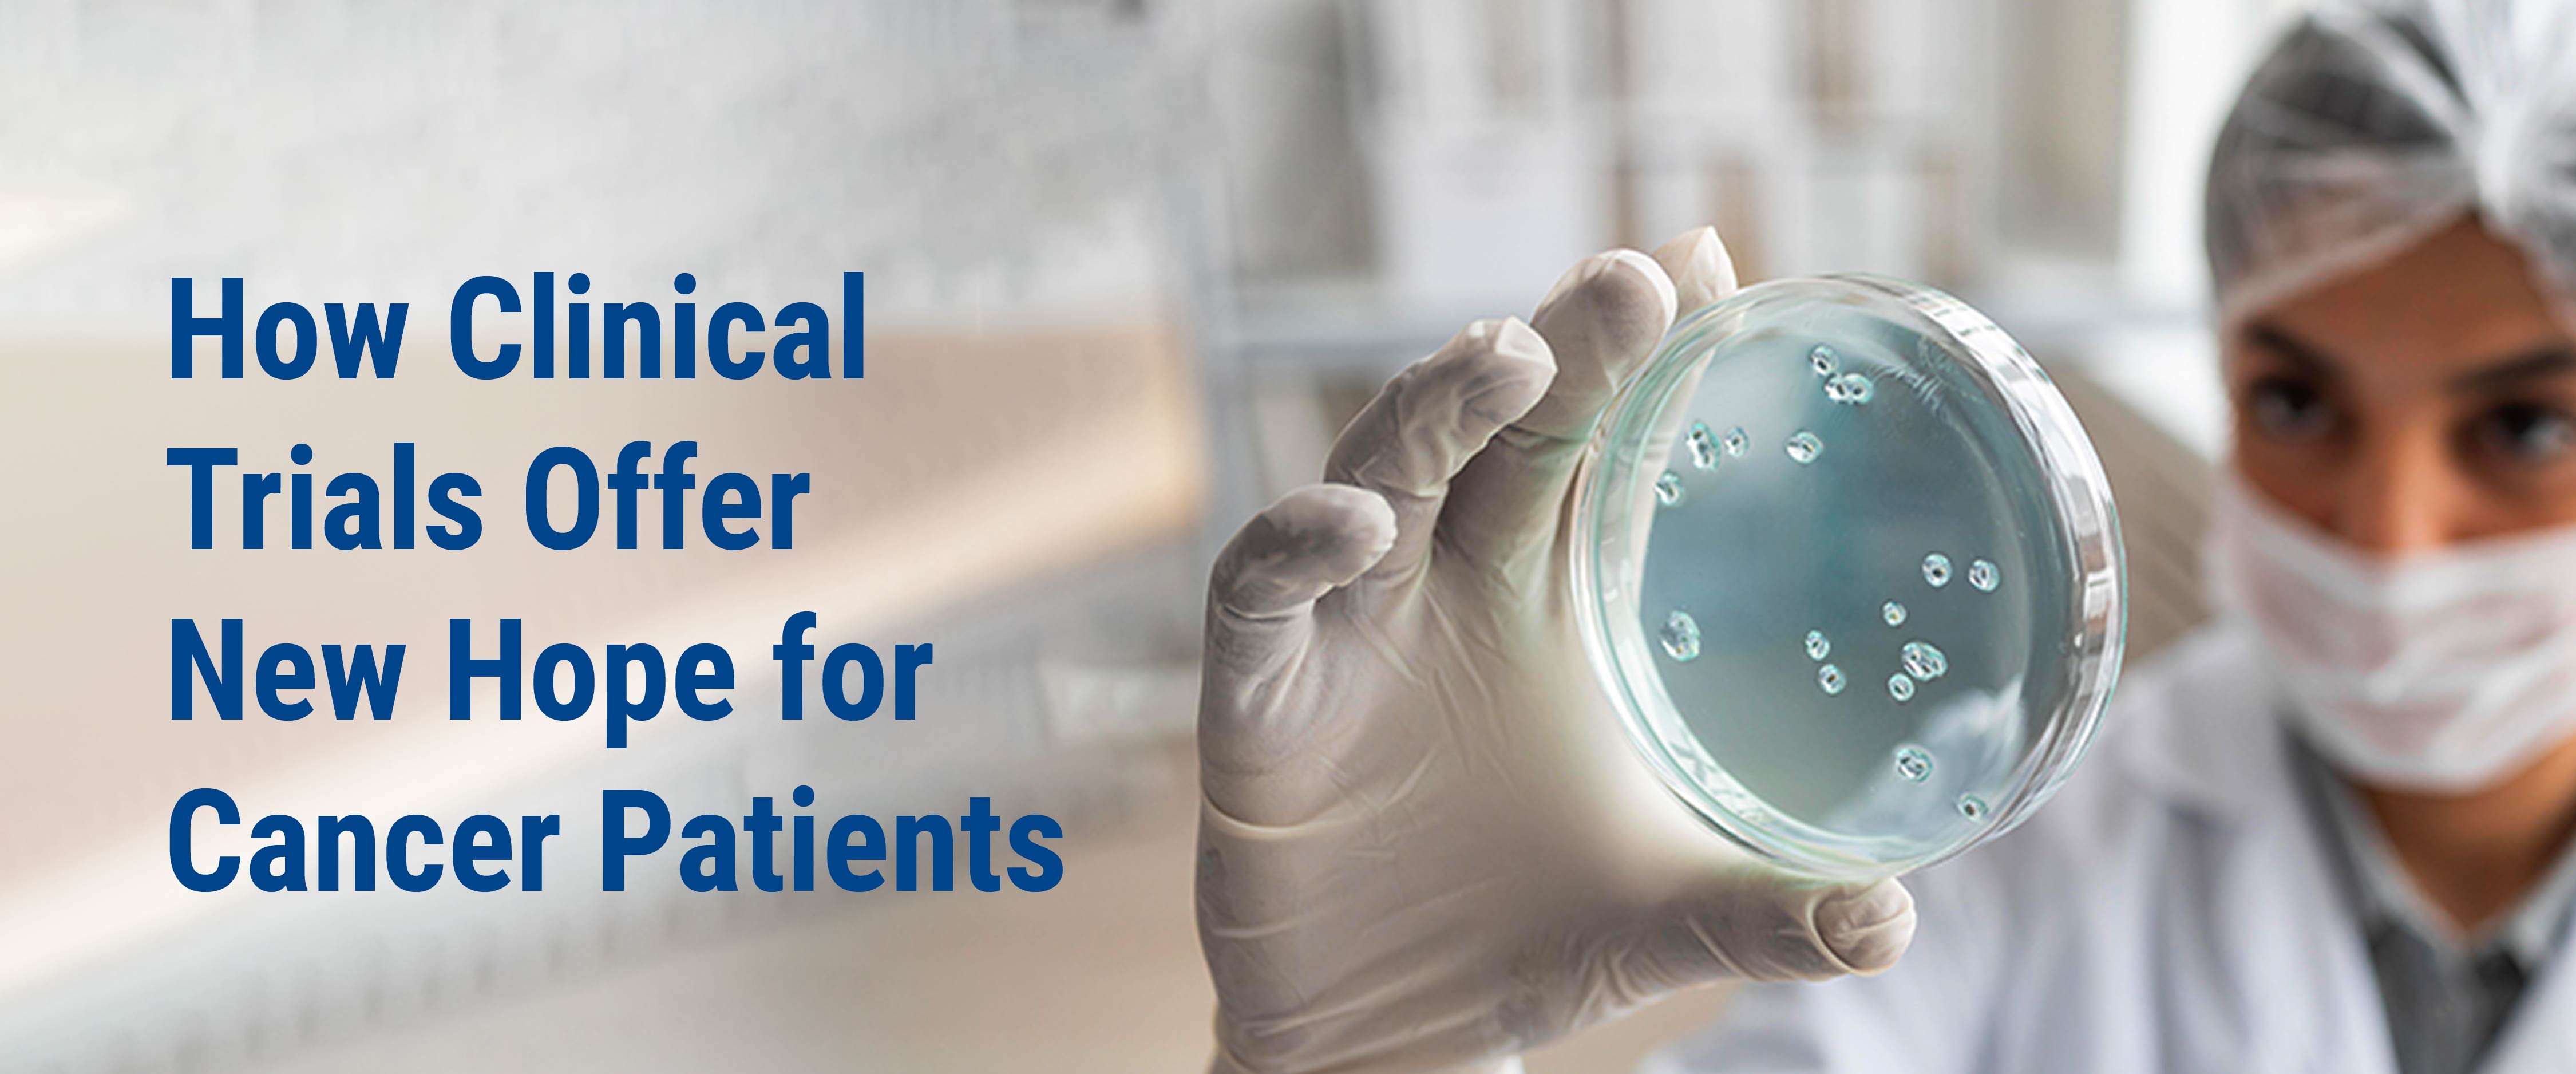

Table of Contents
- What are clinical trials?
- Why are Clinical Trials important?
- What are the risks of clinical trials?
- Are clinical trials safe?
- Who can take part in a Clinical Trial?
- Common Myths about Clinical Trials
Medical science has progressed steadily across all areas of disease and illness. From common aches and pains to complex cardiac conditions and cancer, no health concern is considered insignificant in modern medicine.
This progress depends on careful evaluation of new treatments and interventions. Their safety and effectiveness are established through systematic testing involving patients who voluntarily participate in medical research.
What are clinical trials?
Clinical trials are carefully planned medical studies that test new treatments, drugs, or treatment combinations to see how safe and effective they are. The treatments might be new drugs or devices. These trials may include new medicines, cancer drugs, vaccines, medical devices, advanced radiation techniques, new medicines, immunotherapy, targeted therapy or even new ways of performing surgery.
Why are Clinical Trials important?
Most modern medical treatments used today are the result of successful clinical trials conducted in the past. Clinical trials play a vital role in improving healthcare because they:
-
Help doctors understand cancers better
-
Help discover better and more effective cancer treatments
-
Make future treatments safe and more reliable
-
Reduce the side effects of existing cancer therapies
-
Improve survival and quality of life for patients
Clinical trials help advance medical research. The risks are carefully managed, and patient safety always comes first.
What are the risks of clinical trials?
Like any medical treatment, clinical trials may involve some risks, such as:
-
Side effects from the new treatment, which may be unknown or different from standard treatment.
-
The treatment may not work as expected on some patients.
-
Extra hospital visits, tests, or follow-ups.
-
Emotional stress due to uncertainty.
Are clinical trials safe?
Patient safety is the top priority in all clinical trials. Before a trial begins, it goes through strict scientific, national and international guidelines and ethical checks.
· Clinical trials follow strict safety and ethical guidelines
· Patients are closely monitored throughout the trial
· All known risks are clearly explained before participation
· Patients can withdraw from the trial at any time
Who can take part in a Clinical Trial?
Usually, doctors help decide whether a particular trial is right for a patient because not every trial is suitable for every patient. Eligibility depends on factors such as:
-
Type and stage of cancer
-
Previous treatments
-
Age and overall health
Common Myths about Clinical Trials
If you or a loved one is undergoing cancer treatment, it is a good option to talk openly with your oncologist about:
-
Available clinical trials
-
Potential benefits and risks
-
How the trial may fit into your current treatment plan
For many patients, clinical trials offer new hope and additional treatment options, especially when standard treatments are limited. If you decide to join a clinical trial, know that your well-being is the clinical trial team’s top priority, and you can leave a trial at any time. In fact, many patients feel empowered knowing they are contributing to future cancer cures while receiving advanced care themselves. An informed decision can make a big difference
To learn more about the services at the oncology department of STAR Hospitals, or book an appointment, call 1800-102-7827.